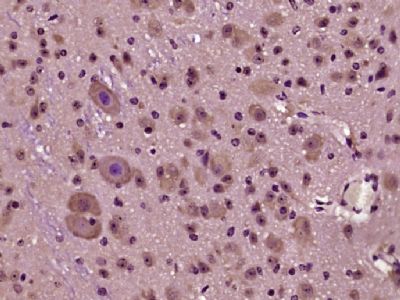
产品封面图

相关产品推荐更多 >
万千商家帮你免费找货
0 人在求购买到急需产品
- 详细信息
- 文献和实验
- 技术资料
- 供应商:
上海联迈生物工程有限公司
- 库存:
大量
- 目录编号:
LM-5392R
- 克隆性:
多克隆
- 抗原来源:
Rabbit
- 保质期:
1年
- 抗体英文名:
phospho-HOMER3 (Thr36)
- 抗体名:
磷酸化HOMER3蛋白抗体
- 宿主:
Rabbit
- 适应物种:
Human, Mouse, Rat, Chicken, Dog,
- 免疫原:
KLH conjugated Synthesised phosphopeptide derived from human HOMER3 around the phosphorylation site of Thr36 [AL(p-T)VS]:AL(p-T)VS
- 亚型:
IgG
- 形态:
Lyophilized or Liquid
- 应用范围:
WB=1:500-2000 ELISA=1:500-1000 IHC-P=1:400-800 IHC-F=1:400-800 IF=1:100-500 (石蜡切片需做抗原修复)
- 浓度:
1mg/ml
- 保存条件:
Store at -20 °C
- 规格:
100ul
| 英文名称 | phospho-HOMER3 (Thr36) |
| 中文名称 | 磷酸化HOMER3蛋白抗体 |
| 别 名 | HOMER3 (phospho T36); p-HOMER3 (phospho T36); HOMER3 (phospho T36); HOMER3 (phospho Thr36); HOMER 3; Homer 3D protein; Homer homolog 3 (Drosophila); Homer neuronal immediate early gene 3; Homer protein homolog 3; Homer3; VESL3; HOME3_HUMAN. |
| 规格价格 | 100ul/1580元 购买 大包装/询价 |
| 说 明 书 | 100ul |
| 产品类型 | 磷酸化抗体 |
| 研究领域 | |
| 抗体来源 | Rabbit |
| 克隆类型 | Polyclonal |
| 交叉反应 | Human, Mouse, Rat, Chicken, Dog, |
| 产品应用 | WB=1:500-2000 ELISA=1:500-1000 IHC-P=1:400-800 IHC-F=1:400-800 IF=1:100-500 (石蜡切片需做抗原修复) not yet tested in other applications. optimal dilutions/concentrations should be determined by the end user. |
| 分 子 量 | 40kDa |
| 细胞定位 | 细胞浆 细胞膜 |
| 性 状 | Lyophilized or Liquid |
| 浓 度 | 1mg/ml |
| 免 疫 原 | KLH conjugated Synthesised phosphopeptide derived from human HOMER3 around the phosphorylation site of Thr36 [AL(p-T)VS]:AL(p-T)VS |
| 亚 型 | IgG |
| 纯化方法 | affinity purified by Protein A |
| 储 存 液 | 0.01M TBS(pH7.4) with 1% BSA, 0.03% Proclin300 and 50% Glycerol. |
| 保存条件 | Store at -20 °C for one year. Avoid repeated freeze/thaw cycles. The lyophilized antibody is stable at room temperature for at least one month and for greater than a year when kept at -20°C. When reconstituted in sterile pH 7.4 0.01M PBS or diluent of antibody the antibody is stable for at least two weeks at 2-4 °C. |
| PubMed | PubMed |
| 产品介绍 | background: This gene encodes a member of the HOMER family of postsynaptic density scaffolding proteins that share a similar domain structure consisting of an N-terminal Enabled/vasodilator-stimulated phosphoprotein homology 1 domain which mediates protein-protein interactions, and a carboxy-termina coiled-coil domain and two leucine zipper motifs that are involved l in self-oligomerization. The encoded protein binds numerous other proteins including group I metabotropic glutamate receptors, inositol 1,4,5-trisphosphate receptors and amyloid precursor proteins and has been implicated in diverse biological functions such as neuronal signaling, T-cell activation and trafficking of amyloid beta peptides. Alternative splicing results in multiple transcript variants. Function: Postsynaptic density scaffolding protein. Binds and cross-links cytoplasmic regions of GRM1, GRM5, ITPR1, DNM3, RYR1, RYR2, SHANK1 and SHANK3. By physically linking GRM1 and GRM5 with ER-associated ITPR1 receptors, it aids the coupling of surface receptors to intracellular calcium release. Isoforms can be differently regulated and may play an important role in maintaining the plasticity at glutamatergic synapses. Subunit: Isoform 1 and isoform 2 encode coiled-coil structures that mediate homo- and heteromultimerization. Subcellular Location: Cytoplasm. Cell junction, synapse, postsynaptic cell membrane, postsynaptic density. Cell junction, synapse. Note=Postsynaptic density of neuronal cells. Similarity: Belongs to the Homer family. Contains 1 WH1 domain. SWISS: Q9NSC5 Gene ID: 9454 Database links: Entrez Gene: 9454 Human Entrez Gene: 26558 Mouse Omim: 604800 Human SwissProt: Q9NSC5 Human SwissProt: Q99JP6 Mouse Unigene: 720208 Human Unigene: 440659 Mouse Important Note: This product as supplied is intended for research use only, not for use in human, therapeutic or diagnostic applications. |
| 产品图片 | ![]() Sample: A549 Cell (Human) Lysate at 40 ug Primary: Anti- phospho-HOMER3 (Thr36) (bs-5392R) at 1/300 dilution Secondary: HRP conjugated Goat-Anti-rabbit IgG (bs-0295G-HRP) at 1/5000 dilution Predicted band size: 40 kD Observed band size: 40 kD ![]() Paraformaldehyde-fixed, paraffin embedded (mouse Cerebellar tissue); Antigen retrieval by boiling in sodium citrate buffer (pH6.0) for 15min; Block endogenous peroxidase by 3% hydrogen peroxide for 20 minutes; Blocking buffer (normal goat serum) at 37°C for 30min; Antibody incubation with (HOMER3 (Thr36)) Polyclonal Antibody, Unconjugated (bs-5392R) at 1:400 overnight at 4°C, followed by operating according to SP Kit(Rabbit) (sp-0023) instructionsand DAB staining. |
风险提示:丁香通仅作为第三方平台,为商家信息发布提供平台空间。用户咨询产品时请注意保护个人信息及财产安全,合理判断,谨慎选购商品,商家和用户对交易行为负责。对于医疗器械类产品,请先查证核实企业经营资质和医疗器械产品注册证情况。
文献和实验Using Phospho‐Motif Antibodies to Determine Kinase Substrates
the phosphorylation site; therefore, substrate?directed, phosphorylation?state?sensitive, motif?specific (?phospho?motif?) antibodies represent powerful tools to identify novel kinase substrates and to investigate mechanisms of substrate phosphorylation
使用 ProteOn XPR36 蛋白相互作用阵列系统 分析抗体 - 膜结合蛋白以及蛋白 - 脂类物质间的相互作用 介绍: 研究细胞膜、膜结合蛋白和抗体间的相互作用以及这些作用的互相影响是药物研发中非常值得关注的事情。膜蛋白和膜相关蛋白以及多肽类物质在很多生物过程中的地位都非常重要,同时还参与到一些诸如癌症等疾病的关键信号通路中。因此,膜蛋白正迅速成为下一代药物靶点分子大类。 ProteOn XPR36 蛋白相互作用阵列系统基于表面
运用Cell Based Elisa检测信号通路蛋白和磷酸化蛋白
results of phosphorylated proteins磷酸化的试剂盒中的抗体是经过大量筛选,选取了高特异性和低背景的抗体。p-P38MAPK抗体是基于P38的磷酸化Thr180到Tyr182这个位点多肽片段所制备。P-JNK抗体是基于人的Thr183和Tyr185.这个抗体可以同时识别P-JNK1和P-JNK2.我们在运用Cell Based Elisa P38和JNK两个试剂盒做检测的同时,又用传统的WB方式来验证这个结果。经过反复验证,都得出了同样的结果, Cell Based
技术资料暂无技术资料 索取技术资料